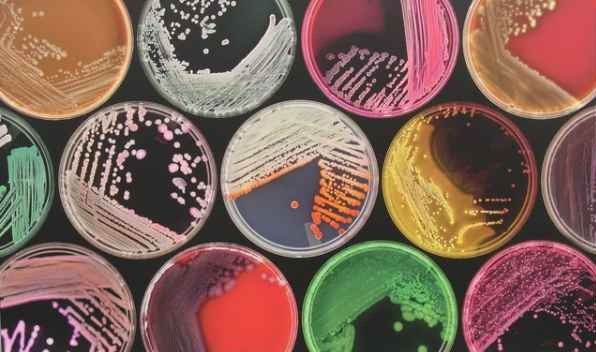
میکروبیوم هر فرد، کلید درمان سرطان

تحقیقات جدید نشان میدهد که باکتریهای موجود در داخل و اطراف بدن، کلید درمان موثر سرطان محسوب میشوند.
روشهای مختلفی، از آنتیبادیها تا واکسنهای گوناگون و شکستن کدهای ژنتیکی برای مقابله با سرطان مورد آزمایش قرار گرفتهاند که تاحدودی در مهار این بیماری مهلک موفق بودهاند؛ اما باکتریهایی که بدن انسان میزبان آنهاست، میتوانند نقش موثرتری در مقابله با سرطان در آینده نزدیک ایفا کنند.
میکروبیوم (Microbiome) مجموع ژنوم تمامی میکروبهایی است که بدن انسان میزبان آنهاست.
بدن انسان میزبان تعداد زیادی باکتری است که در داخل و خارج از بدن، در روده یا پوست انسان زندگی میکنند؛ این اجتماعات میکروبی یا میکروبیوم در ارتباط تنگاتنگی با سلامت انسان هستند.
میکروبیوم در سرطان نیز نقش مهمی ایفا میکند؛ بسیاری از باکتریها تکامل یافتهاند تا دیانای سایر سلولها را بعنوان یک مکانیسم دفاعی تغییر دهند که این مسأله میتواند به شروع یا درمان سرطان منجر شود.
برخی باکتریها در شرایط خاص منجر به بروز سرطان میشوند؛ این در حالیست که برخی از انواع خاص باکتریها میتوانند نقش حفاظتی ایفا کرده و خاصیت سرطانزایی پیدا کنند.
باکتریها از سه طریق میتوانند سرطان را تحت تأثیر قرار دهند: نخست از طریق تغییر دادن تعداد سلولهای تکثیر شده، دوم از طریق اثرگذاری بر سیستم ایمنی و سوم از طریق اثرگذاری بر متابولیسم سلولی. در یک محیط جدید، باکتری میتواند پاسخ ایمنی سلولها را غیرفعال کند یا بصورت غیرضروری این پاسخ را فعال کند که باعث بروز التهاب و شرایط خودایمنی و در نهایت فروپاشی بافت میشود.
در حال حاضر متخصصان میتوانند با دستکاری باکتریها، به سیستم ایمنی برای مقابله با انواع خاصی از سرطان یا باکتریهای عامل بروز سرطان، کمک کنند.
عملکرد درمانهایی که مانند یک موشک، تنها منطقه سرطانی را هدف قرار داده و کل بدن را درگیر نمیکند، از طریق تقویت میکروبیوم محلی تقویت میشوند.
محققان قصد دارند در تحقیقات آتی خود، چگونگی استفاده از باکتریها برای تشخیص سرطان و شناسایی مستعد ابتلا به عوارض جانبی را مورد بررسی قرار دهند که برای درمان طیف وسیعی از سرطانها کاربرد خواهد داشت.
منبع: ایسنا